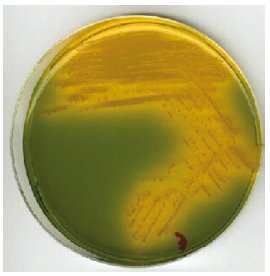

Servicios Personalizados
Revista
Articulo
Indicadores
-
Citado por SciELO -
Accesos
Links relacionados
-
Similares en
SciELO
Compartir
Revista Médica La Paz
versión On-line ISSN 1726-8958
Rev. Méd. La Paz v.17 n.2 La Paz 2011
MISCELÁNEA
HISTORIA DEL CÓLERA EN BOLIVIA (LA PAZ)
Dr. Raúl Arturo Arévalo B*, Dr. Remo Estevéz Martini**
* Past Docente de Microbiología de Facultad Medicina. Universidad Mayor de San Andrés.
** Jefe Departamento de Patología de la Facultad de Medicina, Tecnología Médica, Nutrición y Enfermería de la Universidad Mayor de San Andrés.
El Cólera en América Latina (Cholera morbus) viene de los tiempos de la medicina humoral (teoría de los cuatro humores o humorismo, fue una teoría acerca del cuerpo humano adoptada por los filósofos y físicos de las antiguas civilizaciones griega y romana).
Su raíz parte de dos vocablos:
"morbus" (del latín), que significa enfermedad y;
"chole" (del griego), que se refiere a la bilis; esto es, enfermedad de la bilis.
La historia del cólera en la humanidad se remonta a los antecedentes escritos en China, India y la Grecia.
El cólera, es una de las enfermedades más antiguas del hombre. Aunque no hay consenso respecto del origen del término, existen referencias de Hipócrates (400 AC) y en Sánscrito en Sushruta Samhita (400- 500 AC). Datos fehacientes de la ocurrencia de cólera no estaban disponibles hasta 1817 en que aconteció la primera pandemia documentada en Asia y que se extendió a Turquía y los países árabes, Sticker describió la inscripción en un monolito de los tiempos de Alejandro el Grande, que hacía referencia al verdadero cólera: "Los labios azules, la cara enfermiza, los ojos hundidos, el estómago sumido, los brazos contraídos y arrugados como si estuvieran en el fuego, éstos son los signos de una enfermedad grave, la cual invocada como una maldición por los sacerdotes, humilla y asesina hasta a los más bravos". No se conoce que habría llegado la enfermedad a la Española (América).
En el curso de la segunda pandemia el cólera apareció en América, en 1833 en las costas y altiplano de la República Mexicana, y llega a Cuba aparentemente de España. Simultáneamente, se presentó en las áreas costeras de Guyana sin causar serios problemas. En 1837 Nicaragua sufrió el embate de un devastador brote de la enfermedad.
La tercera pandemia en 1853 atacó la parte norte de América donde llegó a los Estados Unidos, Canadá, México, Colombia y las Indias Occidentales. Durante la tercera pandemia, América registró algunos casos en Centroamérica y Guyana.
Cuarta pandemia, se inicia en 1863, la cual terminó entre 1873, durante el periodo de 1865-1870, el cólera se presentó en forma epidémica en varias islas del Oeste; de Guadalupe ataca Santo Domingo, Santo Tomás, Cuba, y posteriormente los Estados Unidos de Norteamérica. En 1868, una importación del cólera proveniente de Nueva Orleans atacó Nicaragua y Honduras Británicas. La enfermedad se presentó en tropas paraguayas en guerra contra fuerzas combinadas de Argentina y Brasil; Uruguay también fue afectado.
Se considera que desde Argentina el cólera habría llegado a Bolivia y Perú. Ésta parece ser la primera aparición de la enfermedad en estos países de Sudamérica; en 1873, los Estados Unidos de Norteamérica fueron fuertemente afectados, especialmente Nueva Orleans y el área del Mississippi.
Anterior al descubrimiento de la bacteria colérica por Roberto Koch en 1884, la opinión de mayor certidumbre acerca de la etiología del cólera era la del profesor alemán Max Pettenkofer, quien decía que este padecimiento no era ni contagioso, ni miasmático. Él mencionaba que debían de existir cinco condiciones esenciales para la aparición de un brote de cólera: Predisposición individual junto con malos hábitos alimenticios, contacto humano, terreno habitable por seres humanos, poroso y mezclado con aire y agua, variaciones en la mezcla del suelo, suciedad en los suelos.
Corría el año 1883, y de forma repentina estalló en Alejandría una epidemia mortal, que sembraba el terror y el pánico en la Europa mediterránea. Era tan grande el miedo que las calles de Alejandría parecían un desierto, no se sabía quién o quiénes eran los asesinos; se introducía sigilosamente, por la mañana, en hombres, mujeres y niños rebosantes de salud; después de unas horas, los hacía retorcerse con calambres en el abdomen y las piernas, apenas entreabrían la boca y con los labios resecos suplicaban y pedían con voz ajada y ronca "agua"... para poder mitigar su sed, sus ropas se encontraban completamente mojadas y manchadas por los desechos intestinales que desbordaban del ano sin poderlos contener poniendo en muy pocas horas aquel cuerpo humano completamente seco, y ya para la noche estaban secos, fríos y duros, habían escapado de las garras de todo sufrimiento. Así era el cólera morbus, imprevisto, rápido, y certero.
La quinta pandemia hizo su aparición en 1881 y terminó en 1896, en 1887, Nueva York sufrió de los estragos de esta enfermedad y serios brotes tuvieron lugar en Sudamérica, especialmente en Argentina y Chile en el periodo 1886-1888.
El cólera reapareció en Nueva York en 1892. En los inicios de la pandemia, el cólera apareció en Sudamérica, incluyendo Brasil de 1893 a 1895, Argentina en 1894 y 1895 y Uruguay en 1895.
Sexta pandemia se inicia en 1889 no se tienen datos de que hubiese penetrado en las Américas (Howard-Jones, 1974).
La séptima pandemia se inició en 1961 en Sulawi (Célebes) en Indonesia, extendiéndose al subcontinente índico y al Oriente Medio, lo que obligó a tender cordones militares y a usar obligatoriamente el cloranfenicol en los viajeros procedentes de países endémicos de la enfermedad. Sin embargo, el cólera avanzó al Occidente, seguramente propiciado por las comunicaciones aéreas.
Para 1970, el cólera llegó a África, donde el país más afectado fue Nigeria, de ahí se trasladó a los países del Mediterráneo, con lo que Europa padeció nuevas epidemias; uno de los brotes más graves ocurrió en Italia en 1973. Asia también sufrió el ataque de la enfermedad; en la India fueron atacados los refugiados de la guerra India-Paquistán, situación que fue aprovechada para probar la eficacia de la rehidratación oral.
En1991,la epidemia llegó a Latinoamérica; el primer caso se registró en Perú el 23 de enero. Los casos de Perú indicaron el inicio de la primera epidemia de cólera en América Latina de este siglo. El 7 de febrero de 1991, se conoce oficialmente la presencia de un brote de cólera en la República del Perú. Se aisló por primera vez en las ciudades de Chancay, Piura y Chimbote, el 23, 26 y 29 de enero de dicho año, las tres eran ciudades costeras que de manera simultánea avisaron de un brote de la bacteria del Vibrión Cholerae 01 toxígeno, Biotipo El Tor, serotipo Inaba.
Los datos conocidos para el 18 de mayo del 1991 fueron de 200.785 casos, de los cuales 78.671 fueron hospitalizados y fallecieron 1.654; lo que dio una tasa de ataque de 0.9% (N° Casos/ población expuesta por 100), y una tasa de letalidad de 0.8% (N° de fallecidos/ N° casos por 100).
También es importante saber cómo se originó y a causa de que se diseminó tan rápidamente. La teoría epidemiológica señala como una posible fuente de origen al mar, a través de una contaminación masiva del fitoplancton, peces y mariscos de la zona caliente del mar peruano, hacia el Norte de Lima, lo que también explicaría con mejor precisión el carácter explosivo que afectó más de 1,200 Km. en menos de dos semanas. Además el hábito de comer pescado y mariscos semicrudos (cebiche), permitieron la rápida contaminación de los poblados. La extraordinaria precisión con que afectó sólo a la población de escasos recursos y pobre saneamiento ambiental, sin agua ni desagüe y con pobre sistema de eliminación de aguas servidas.
Con este panorama tétrico, y con las noticias que fallecían de 11 a 12 ciudadanos peruanos cada día, de diferentes edades y de ambos sexos, las autoridades bolivianas de esa época conforman los Comités Intersectoriales de Lucha Contra el cólera, entre los que destaca la labor de la facultad de Medicina de la Universidad Mayor de San Andrés, que conforma las brigadas de educación y capacitación, que llevan la suficiente información a nivel de las escuelas fiscales y particulares de La Paz, es también de destacar el compromiso total de las y los profesores de todos los niveles, que vigilan el ingreso a los kínderes, donde los pequeños deben portar su propio material de aseo personal (jabón, toalla, crema dental y su cepillo), labor que no hubiese logrado el cometido de controlar la inminente invasión de la tan temida bacteria en la población paceña, si los padres de familia de forma militante no hubiesen cumplido con dichas exigencias.
Como estrategia principal estuvo la campaña de prevención contra el cólera, se despliega una intensa labor de difusión, información y educación en todos los niveles de la población, y por todos los medios de comunicación social, oral, escrita y televisiva.
El 14 de febrero de 1991 mediante Decreto Supremo N° 22899, se declara al país en emergencia nacional. Mediante las Resoluciones Ministeriales emitidas por el Ministerio de Previsión Social y Salud Pública, N° 0067, N° 0068, se declara al personal de la Seguridad Social y del Subsector Pública de Salud, en emergencia nacional, debiendo estar en situación de alerta para ser convocados en cualquier momento, disponiéndose además que los servicios de internación, laboratorio, y de diagnóstico de los hospitales regionales de segundo y tercer nivel de todo el país, para que se dispongan del número adecuado de camas libres para la atención de probables enfermos de cólera.
La Resolución del 8 de febrero de 1991, N° 24451/91, regula el ingreso de algunos alimentos procedentes de los países afectados.
Además, una articulación constante entre el sector salud, educación y comunidad es primordial para que la población haya podido sobrevivir al ataque. El enfoque de riesgo fue el método que se empleó para medir la necesidad de atención por parte de grupos específicos. También se usó como una herramienta para definir las necesidades de reorganización de los servicios de salud y ayuda a determinar prioridades de salud.
La detección temprana de los casos también permite identificar tempranamente a los contactos de las casas y ayuda a la autoridad a investigar cómo se está propagando el cólera, para que se puedan tomar medidas de control específicas. Se promovió la ayuda de miembros de organizaciones voluntarias, líderes sociales, profesores, estudiantes y otros miembros de la comunidad, proveyéndoles información sobre la ocurrencia de casos.
En condiciones de vida que se vive en los países en vías de desarrollo insalubres, la contaminación del ambiente que rodea a las personas es casi inevitable la transmisión del vibrión del cólera.
Se hacen recomendaciones específicas si ocurrieran entierros de aquellas personas que mueren a consecuencia del cólera debiendo ser realizados en forma rápida, cerca del lugar de la muerte, se debe limitar reuniones con motivo del funeral, el lavado ritual de los muertos o las festividades que siguen a un funeral en algunos lugares deben postergarse. Los funerales pueden hacer que vengan personas de un área no infectada a un área infectada, desde donde pueden llevar el organismo del cólera de regreso a sus casas.
Entre otras actividades se procedió al Control Sanitario, Supervisión y Vigilancia Epidemiológica; se desarrolla un sistema de seguimiento de la curva de comportamiento de diarreas, como el primer marcador biológico, para detectar en forma temprana, la presencia de un posible brote de cólera y, de esta manera, realizar las acciones pertinentes inmediatas para evitar su diseminación y realizar un adecuado control, por lo que se intensificó la notificación de diarreas en todo el país, tanto en menores y mayores de 5 años. Debiéndose recibir los informes de todas las Unidades Sanitarias, para hacer posible observar el comportamiento de esta enfermedad.
El 3 de abril de 1991, se inició la investigación del Vibrio cholerae en Bolivia, con el objetivo de detectar la presencia del vibrión en personas sospechosas, en los ríos, alcantarillas, cursos de agua, en las ciudades principales del país.
Se incrementa las actividades de supervisión y vigilancia epidemiológica en las zonas fronterizas con el Perú.
Cinco misiones de médicos y técnicos nacionales se desplazan a Puno, visitando las ciudades de Puno, Juliaca, Tukawacas y Suches, el 20 de febrero, se atendió un brote epidémico en Juliaca, donde 37 personas presentaron signos y síntomas de cólera, falleciendo tres. La ayuda boliviana consistió en 1.500 tratamientos de antimicrobianos y apoyo técnico para los pacientes y sus contactos, lográndose el control del brote en dicha región.
Se inicia en el país la detección de la bacteria en aguas de consumo y en las redes de alcantarillado, para tomar medidas de control sanitario y epidemiológico, además de la búsqueda de portadores asintomáticos, se realiza rastrillaje en busca de diarreas sospechosas, desinfección de las aguas contaminadas con el vibrión, además de la identificación de las áreas de riesgo.

El país, particularmente La Paz inicia el trabajo de investigación bacteriológica con la metodología que se cuenta en ese momento, encontrándose diversas dificultades como las que no se tienen el material básico (medios de cultivo específico para el desarrollo de la bacteria como el medio de cultivo Agar Tiosulfato Citrato Bilis Sacarosa -TCBS, discos de oxidasa) para la implementación de dicho trabajo, de tal manera que el equipo de trabajo se enriquece en marzo del año 1991, con el retorno del continente asiático después de haber cumplido con una beca otorgada por el gobierno del Japón, del Dr. Remo Estevéz M, quien no sospechaba que a su retorno su vida profesional sufriría un cambio trascendental, porque al día siguiente de haber llegado a la ciudad de La Paz, se dirigió a la oficina del Director del Instituto Gastroenterológico Boliviano Japonés (I.G.B.J) Arnold Hoffman Bang-Soleto(+) y al ser el responsable del área de Bacteriología, debía de manera inmediata presentarse a la Unidad Sanitaria con el Director, Dr. Guido Monasterios; producto de dicha reunión tuvo que viajar a la localidad fronteriza con Perú denominada Desaguadero, para conformar el Comité de Vigilancia de Prevención contra el Cólera junto a otros personeros del Ministerio de Salud, Municipalidad y Aduana.
Durante dos meses en dicha localidad conjuntamente con el interno del hospital, el jefe de grupo Dr. Magne y Dr. Estevéz realizaron charlas orientadas a la prevención del Cólera. Al retorno a las actividades cotidianas tanto en la Facultad de Medicina como sus funciones de Bacteriólogo en el I.G.B.J.
A su regreso a sus labores en la Facultad de Medicina de la UMSA. fue nuevamente convocado por la Unidad Sanitaria y se le nombra Miembro del Consejo de Vigilancia Bi Nacional (Perú -Bolivia) para la Prevención del Cólera).
A órdenes del Dr. Roberto Vargas entonces director de Epidemiología se conformó un equipo multidisciplinario cumpliendo una ardua labor conjuntamente con el Dr. Virgilio Prieto, Dr. Elio Calvo y otros colegas se continúa con el trabajo inicial en el Perú fue por el lapso aproximado de cuatro meses realizando viajes semanales a diversas localidades del Perú, para colaborar tanto en el aspecto de Diagnóstico Bacteriológico como así en el aspecto epidemiológico también dando charlas y varios cursos para así coadyuvar y evitar el ingreso del Vibrio cholerae hacia nuestro país ya que en la entonces denominada Región José Mariátegui ya se habían presentado casos positivos de la enfermedad.
Mientras tanto, el 5 de mayo de 1991, se conformó el equipo de investigación, en la ciudad de La Paz, y estuvo conformado por los Responsables de las Unidades Sanitarias (U. S); por la U. S de El Alto, como Responsable Dr. Héctor Pérez, como Responsable de la U. S La Paz -Centro piloto- Dr. Johnny Mollinedo, y como responsable de la Dirección Nacional de Epidemiología: Tec. Teresa Ruíz.
El universo de trabajo, se consideró a todo el territorio boliviano, determinando como puntos críticos a ser rastreados, mediante una selección utilizando mapas del sistema recolector de alcantarillados y ríos, proporcionados por las entidades correspondientes en cada departamento.
La vigilancia consistió en la recolección de muestras de 15 puntos (alcantarillas), 9 en la ciudad de La Paz, y 6 puntos (alcantarillas) en El Alto.
La recogida de las muestras se realizó por los valientes técnicos de la Unidad Sanitaria de El Alto y DIRNALEP, los que utilizando guantes de goma y usando barbijos, abrían las tapas de las alcantarillas y colocaban los hisopos de Moore de tal manera que entrara en contacto por 24 horas con las aguas servidas que corren por el interior de las alcantarillas, posterior a 24 horas, se constituían nuevamente para recoger los hisopos de Moore, humedecidos y mal olientes para colocarlos en el interior de los frascos con capacidad de 500 ml, que contenía 250 ml agua alcalina peptonada (APA) con un pH 8.8, con fecha y hora determinada para la recolección. Luego era transportada al laboratorio responsable que en La Paz estaba a cargo del laboratorio del Hospital Obrero, cuyo responsable era el Dr. Eduardo Camacho y el Dr. Raúl Arévalo B., quienes vestidos con escafandras iniciaban la recepción de las muestras para luego colocarlas en la incubadora a 35°C por el espacio de 6 horas, trascurrido dicho tiempo se procedía abrir los envases que contenían un líquido verde, caliente y burbujeante, que además despedía el olor pestilente de aguas servidas incubadas, que rápidamente se difundían por todo el primer piso donde se encontraba el laboratorio, en el hospital Obrero N°1. El trabajo se vio privado de la presencia del Dr. Camacho puesto que por motivos de salud tuvo que viajar al Beni, quedando como responsable el Dr. Arévalo, quien tomando las precauciones necesarias dejó de utilizar las escafandras para continuar con el trabajo. El mismo que tuvo una brusca interrupción al ser notificado por la Jefe del Laboratorio que debía abandonar el laboratorio, porque era insoportable el mal olor, "hiede como heces", fue el motivo para que sí o sí se tuviera que cambiar de lugar. La pregunta era en ese momento, donde llevar el material y continuar con este noble trabajo en beneficio del país. Muestras, medios de cultivo y Dr. Arévalo, tuvieron que abandonar ese centro de trabajo, pero al ser docente de la Cátedra de Microbiología de la Facultad de Medicina de la UMSA armó el nuevo lugar de trabajo en un cuarto pequeño que estaba en el sexto piso y que servía de depósito de libros, se armó el nuevo lugar del trabajo, "Laboratorio".
Durante 43 días (14 de mayo al 27 de junio de 1991), se logró analizar más de 138 muestras, durante las largas horas nocturnas de trabajo, el responsable, tuvo la compañía del Dr. Carlos Laforcada, quien fumando tediosamente un cigarro hacía que el trabajo sea menos agotador.
Se procedía a la siembra a partir del medio de transporte (APA) al medio de TCBS, y una vez que desarrollaban las colonias sospechosas se realizaba la prueba de la oxidasa (3 fueron positivas), las que se enviaban al IGBJ, donde eran reanalizadas por el Dr. Estevéz.

FORMA DE TOMAR LAS MUESTRAS DE AGUA PARA DETERMINAR VIBRIO CHOLERAE
1. Se toman muestras de aguas no tratadas, que se tiene la sospecha de haber sido contaminadas con residuos fecales con Vibrio cholerae.
2. Se llena el frasco hasta la línea haciendo un volumen de aproximadamente un 450 ml, cuidando de no botar la solución de APA.
3. Se llena el formulario de envío correctamente indicando la hora de toma de muestra, de ese momento se inicia el período de incubación, lo mismo se rotulará el frasco con lápiz que no se despinte.
4. Se evita que las muestras entren en contacto con los rayos del sol.
5. Las muestras son transportadas al laboratorio, no deben de pasar más de cuatro horas después de haberlas tomado.
PREPARACIÓN DEL HISOPO DE MOORE:
1. Preparación del hisopo de Moore. Se corta un trozo de gasa de 90 cm. de ancho x 180 cm. de largo. La gasa se dobla 5 veces en sentido longitudinal obteniéndose las siguientes dimensiones: 30 cm. de ancho por 36 cm. de largo. A partir de la base de inferior de 30 cm. se cortan 6 tiras de 5 cm. de ancho y 26 cm. de largo dejándose 10 cm. en la parte superior sin cortar. En este sitio se amarra con un cordón de nylon o de otro material fuerte. Se coloca en papel madera y se autoclava a 121°C durante 15 minutos.
2. En el lugar de recolección de la muestra se abre el paquete que contiene el hisopo y se ata un tejido de nylon (o de otro material fuerte) a la zona ligada del hisopo. Luego se sumerge completamente el hisopo en el curso de agua que se va a muestrear y amarrar el extremo del tejido en un lugar seguro. Se controla que el hisopo quede bien sumergido, colocando los hisopos en sitios seguros para evitar que personas ajenas lo retiren de su sitio.
3. Se deja el hisopo en el sitio a muestrear durante 24 horas como mínimo.
4. Se retira el hisopo y se lo coloca con mucho cuidado en un frasco que contiene 250 ml de agua peptonada alcalina (APA, con pH 8.4 a 8.6). Se evita que el agua residual tome contacto con la parte exterior del frasco. Todo este procedimiento se realiza con guantes. En caso de que las manos y el frasco se manchaban externamente se desinfectaba con agua e hipoclorito de sodio.
5. Las muestras son identificadas y toda la informaci6n sobre las mismas deben de ser completada: número de muestra, fecha y hora de toma, tipo de agua, funcionario que tomo la muestra, para que los resultados puedan ser interpretados correctamente.
6. Se registra en el frasco la fecha y hora de muestreo y remita inmediatamente sin refrigeración al laboratorio.
7. A su llegada al laboratorio se incuba el frasco de APA durante 6 a 8 y 18 horas entre 35 - 37o C.
8. A las 6 a 8 H se efectuaba el primer aislamiento en agar TCBS por 24 horas, luego se resiembra en el frasco de APA.
9. A las 18 horas se efectúa un segundo aislamiento del caldo APA en -placas de TCBS.
10. En agar TCBS las colonias de Vibrio cholerae aparecen amarillas (fermentadores de sacarosa) con bordes lisos, el medio de cultivo inicialmente es de color verde.
11. Se continúa con las colonias sospechosas efectuando pruebas bioquímicas de la oxidasa.
12. Las muestras que eran positivas a la prueba de la oxidasa eran remitidas al IGBJ.
![]() |
| Desarrollo de colonias del Vibrio Cholerae a partir de muestras recolectadas de las aguas de las alcantarillas de las ciudades de La Paz y del Alto. |
Lamentablemente la vigilancia tuvo que ser bruscamente interrumpida a finales de junio por la falta de reactivos, puesto que no había en existencia en ninguna tienda importadora del país.
Mientras tanto en el vecino país las medidas tomadas habían logrado que los casos se hubieran mantenido o estaban disminuyendo, todo parecía controlado, pero llegó el fatídico 26 de Agosto de 1991 cuando se reporta la sospecha de un caso de cólera en una persona natural de la zona denominada El Palomar (Rio Abajo), que había retornado de un viaje hacia la frontera con Perú ; inmediatamente se declara Alerta Roja en el País y se conforman brigadas para salvaguardar la vida de los bolivianos, sin embargo la Séptima Pandemia de Cólera había ingresado al país NO! por donde era lógico que ingresara (la larga extensión territorial fronteriza con Perú), ingresó por donde absolutamente nadie se imaginaba (Rio Abajo).
A los pocos días del caso inicial comenzaron a diagnosticarse en progresión geométrica los casos positivos del temido mal. El Dr. Estévez, al ser miembro del Comité de Vigilancia para la Prevención del Cólera y el I.G.B. J. pone en práctica todo lo aprendido en el Japón.
Se trabajó "full time" en los diagnósticos (aunque particularmente consideraba que ya no había necesidad de seguir haciéndolo ya que existían muchos casos positivos comprobados por los mayores métodos diagnósticos de la época puesto que gracias a sus mentores de Oriente al enterarse de la magnitud del problema no dudaron en enviarle materiales, reactivos, medios de cultivo y pruebas bioquímicas que ninguna Institución de salud en el país tenía para realizar los diagnósticos a cabalidad, ya que por si fuera poco pudo contar con pruebas antigénicas y poder determinar los serovares que existían en relación al Biotipo El Tor que ya había tipificado.
En vista que la ciudad de La Paz fue la primera ciudad en ser agredida por el Vibrio cholerae, su trabajo tuvo continuidad al seguir trabajando en el resto del país y difundiendo la experiencia y conocimientos adquiridos fuera y dentro de nuestras fronteras.
El año 1993, el Dr. Estevéz conjuntamente con los profesores de la Facultad de Medicina Carlos Aguirre C. y Elvin Mollinedo P. se ausentaron a un curso en Beer-Sheva en la Universidad Ben Gurión (Estado de Israel), donde participaron en un evento relacionado a enteropatógenos con énfasis en Cólera y tiempo después a su retorno recibieron un "Dossier" en el cual se publicaba como recomendación lo propuesto por la delegación de Bolivia en relación al diagnóstico bacteriológico del Vibrio cholerae y se descartaban las proposiciones diagnósticas de otras delegaciones de Latinoamérica.


La epidemia del cólera en Bolivia, durante 1991, no se comporta, de forma explosiva, como se esperaba en conglomerados humanos, que tienen los mejores factores (condiciones de pobreza, saneamiento ambiental deficiente o no existe, además de hábitos higiénicos de alguna parte de la población (fecalismo al aire).
La expansión de la enfermedad se presentó desde el 22 de agosto hasta el 28 de diciembre de 1991 como se observa en el cuadro N° 1.

"En la actualidad tenemos otros desafíos, que estamos preparados para aceptarlos en beneficio de nuevas generaciones de estudiantes y porque no parangonar a Paul de Kruif: en beneficio de nuevos "Cazadores de Microbios" (REM).
REFERENCIAS
1. Kruif P. Cazadores de Microbios. 1998 [ Links ]
2. Arita M, Takeda T, Honda T, Miwatani T Purification and characterization of Vibrio cholerae Non-01 heat-stable enterotoxin. Infect Immunol 1986;52:45-9. [ Links ]
3. Kumate, J.; Sepúlveda, J. y Gutiérrez, J. (1993). El cólera. Epidemias, endemias y pandemias. Interamericana-Mc Graw-Hill. [ Links ]
4. Howard-Jones, N. (1974). "Cholera Nomenclature and Nosology: A Historical Note", en Bull World Health Organization. 51: 317-324.